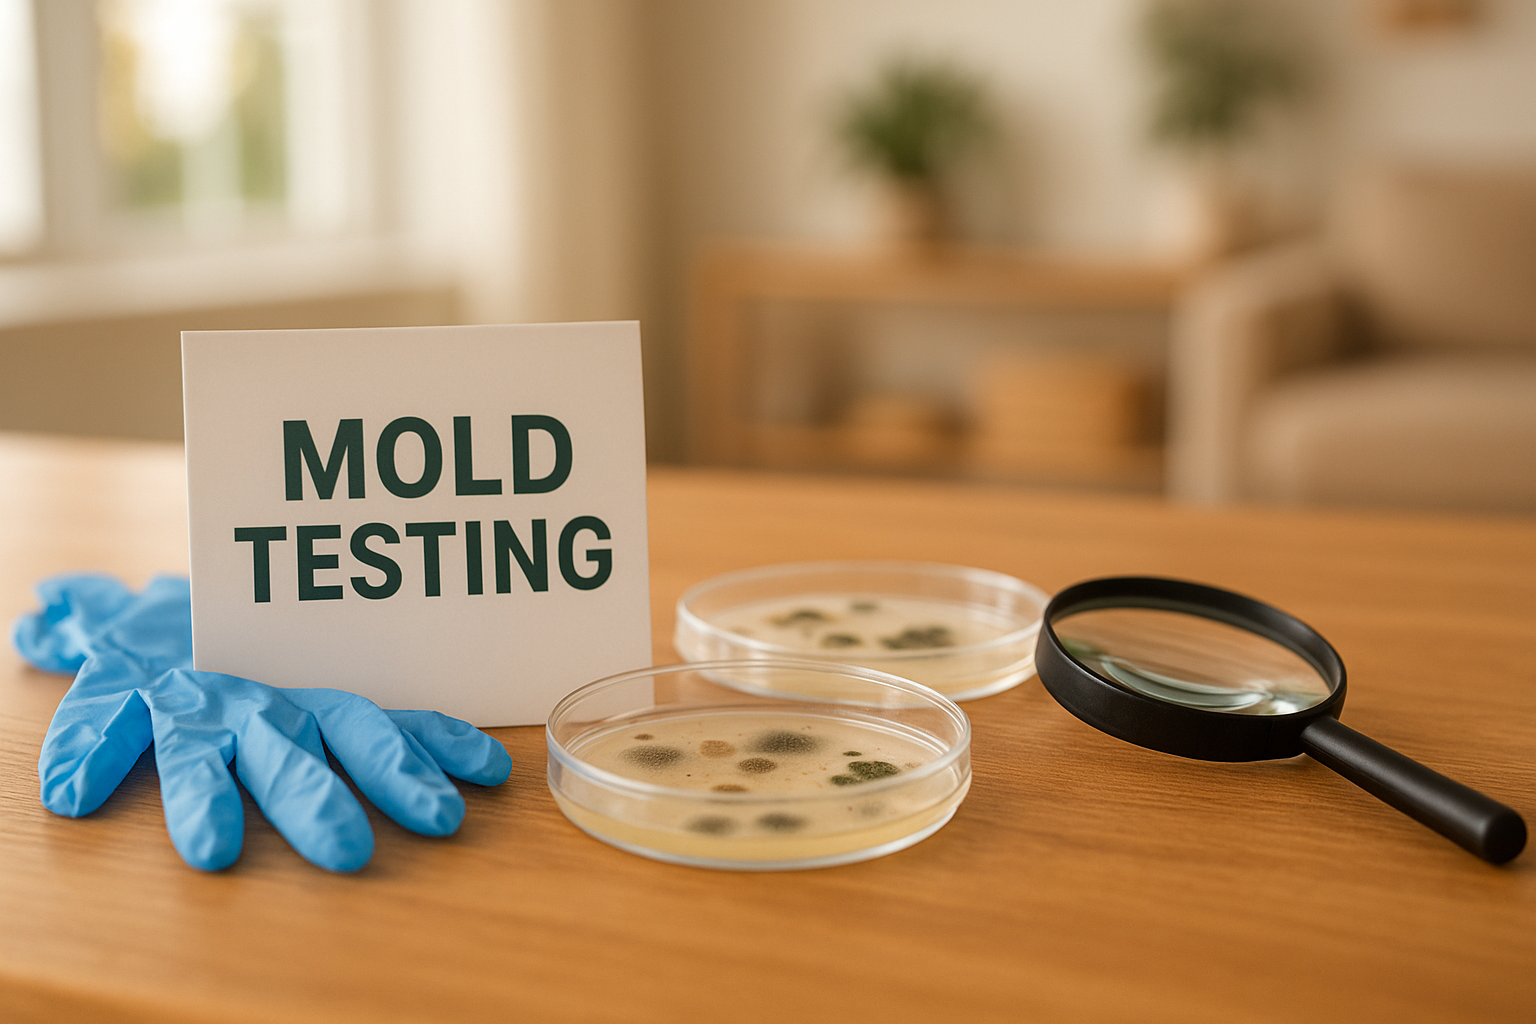
can you test for mold in your home yourself the ultimate guide
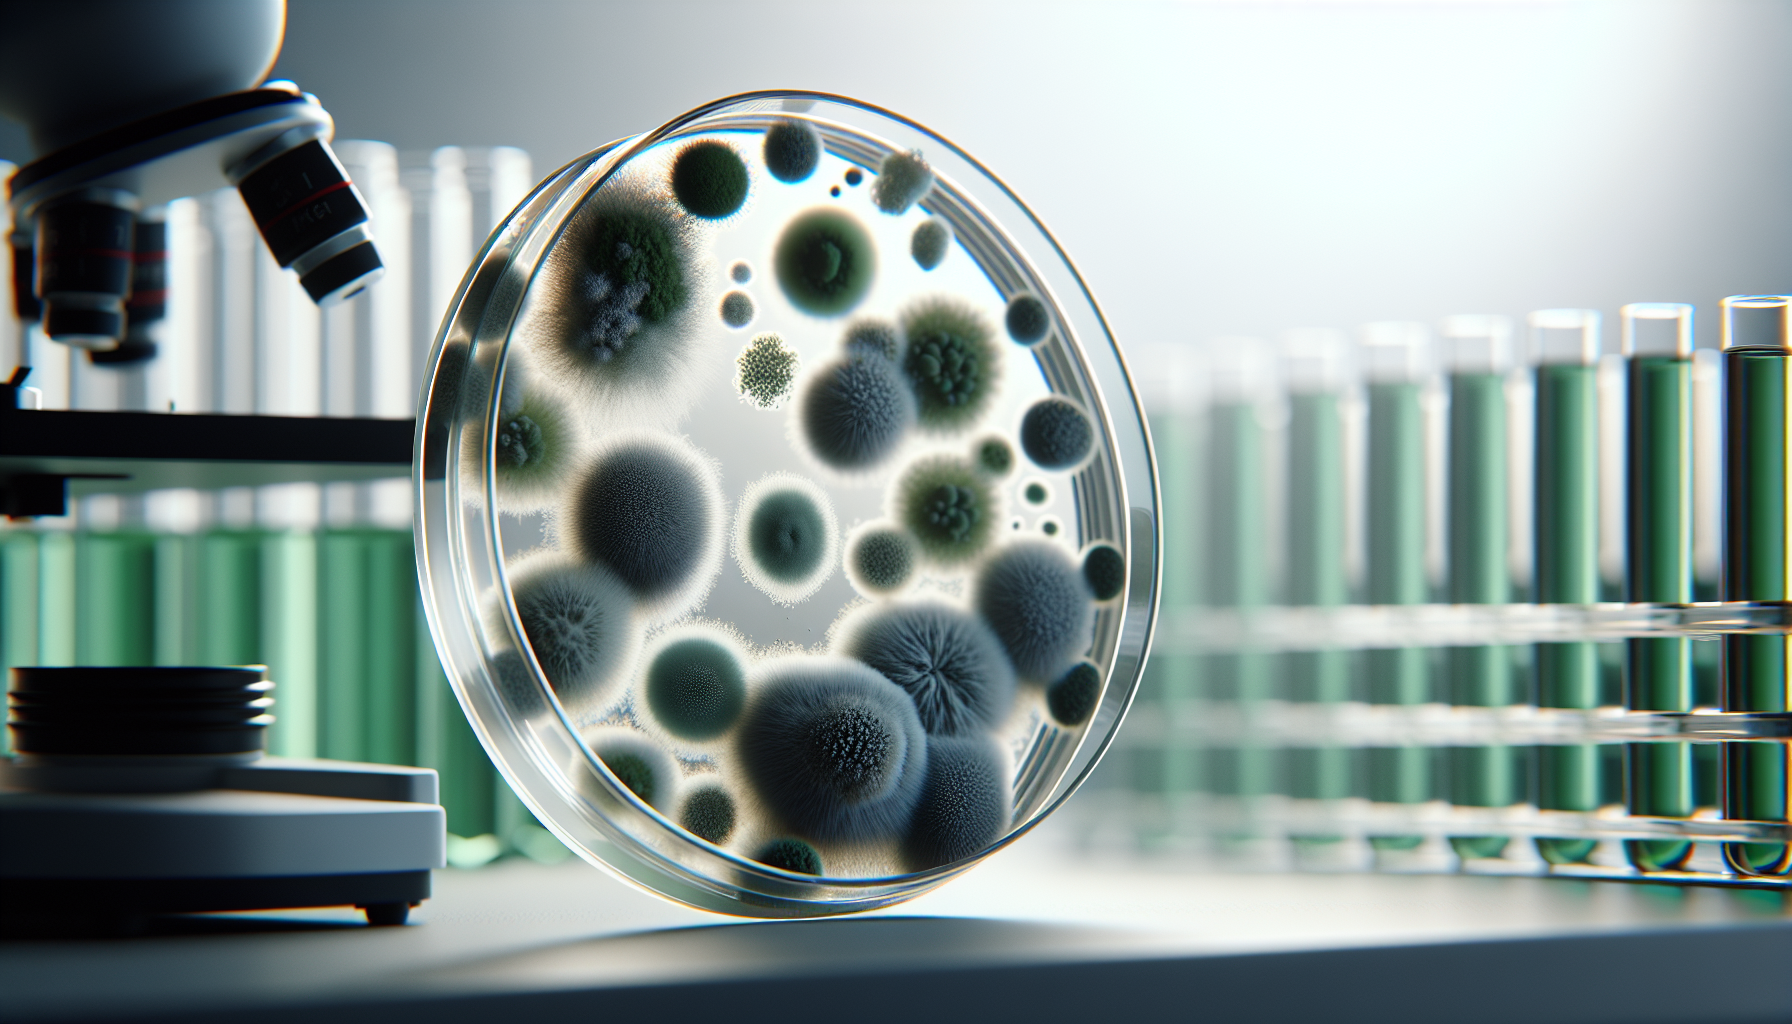
are mold toxicity tests legit

How to Test for Mold in the Air in Your House? The Ultimate Guide
How to Test for Mold in the Air in Your House? The Ultimate Guide: 11 Expert Steps for 2026 You usually search How to test for mold in the air in your house? for one of three reasons: your home smells…
How to Test for Mold in the Air in Your House? The Ultimate Guide Read More »